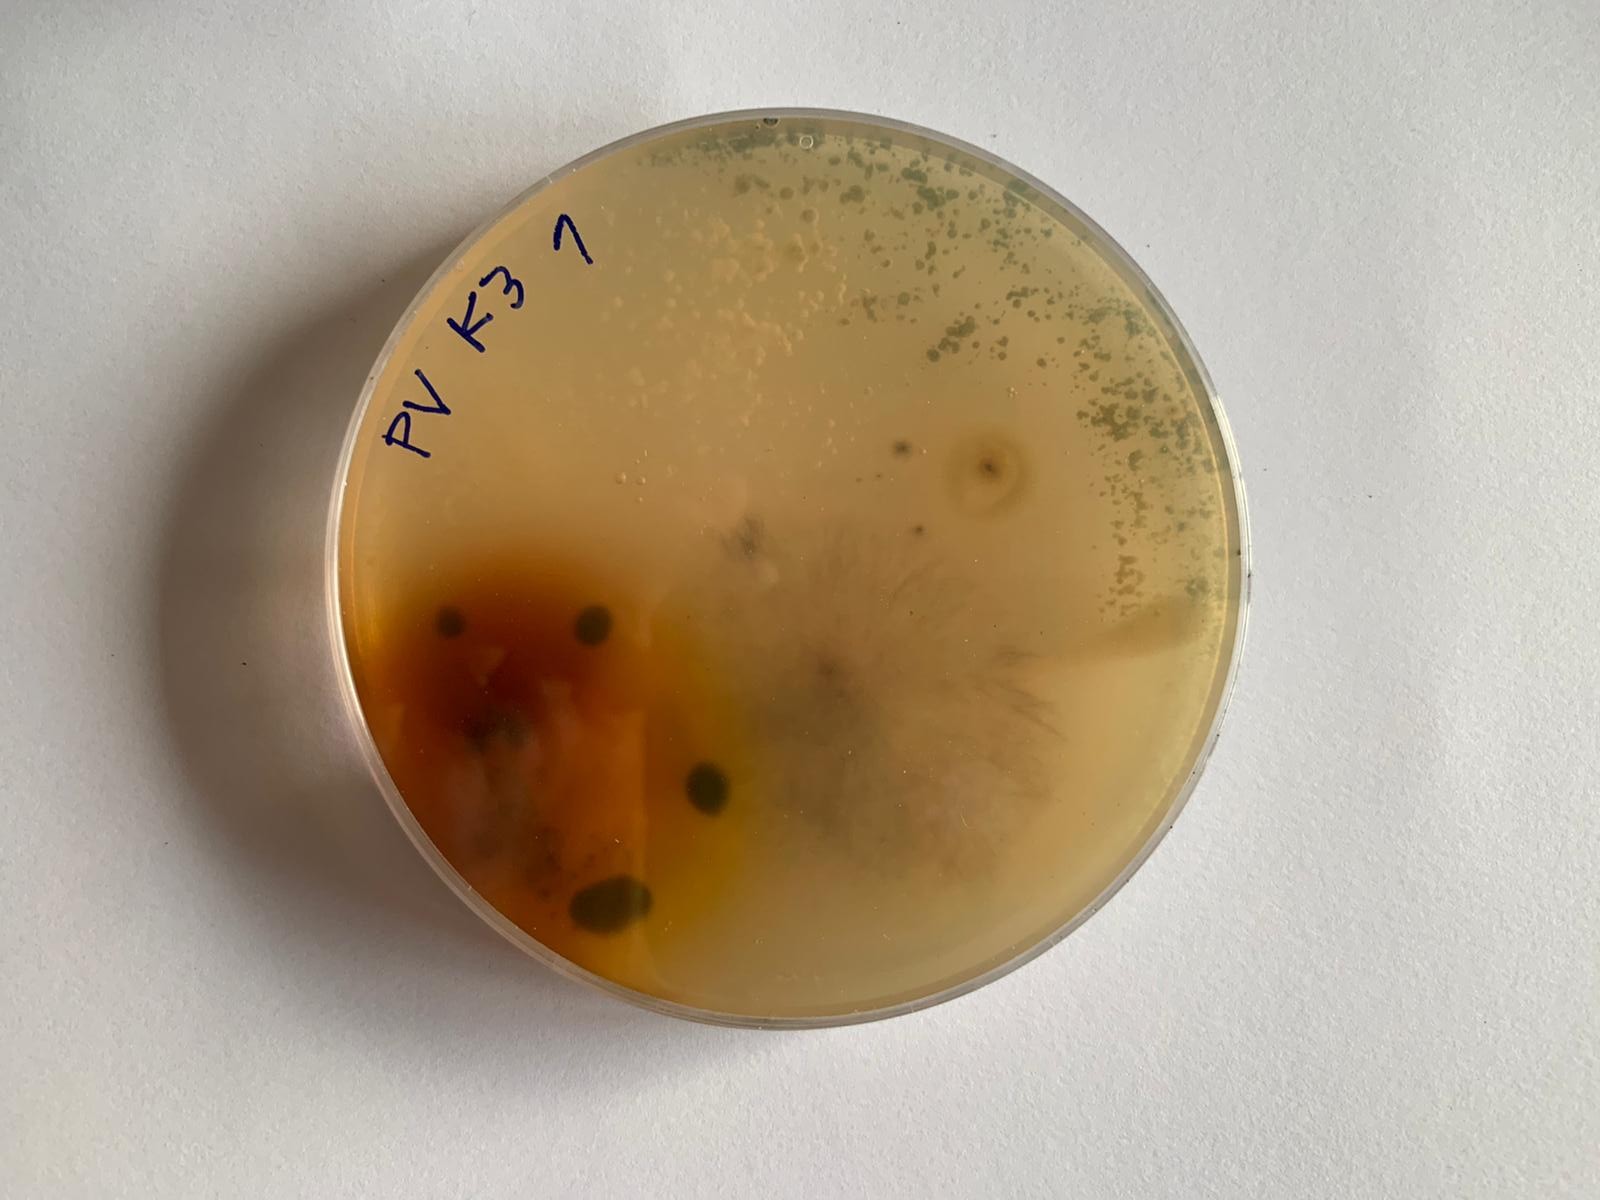

Colección Bahía de Montevideo
Desde el Museo de Arte Contemporáneo de Montevideo planteamos un ejercicio plug-in a las expediciones organizadas por el proyecto Territorio Específico y los colectivos asociados.
Invitamos a la construcción colectiva de una colección de elementos orgánicos e inorgánicos, recolectados en el tránsito por los diferentes lugares propuestos en las expediciones.
Estos lugares dan cuenta de diferentes ecosistemas que se han construido a lo largo del tiempo y en los que es posible indagar sobre las relaciones que establecen el ser humano con su entorno, así como los diferentes elementos que los componen entre sí.
¿Qué tiene para decirnos un elemento de su situación en el territorio? ¿Cuál es su relación con la intervención del ser humano? ¿Qué vemos en las cosas? ¿Qué escapa a nuestra mirada? ¿Es posible dar la palabra a estos elementos? ¿Es posible construir un relato colectivo entre estos materiales, sus voces y nuestras intervenciones?
Desde el Museo de Arte Contemporáneo de Montevideo planteamos un ejercicio plug-in a las expediciones organizadas por el proyecto Territorio Específico y los colectivos asociados.
Invitamos a la construcción colectiva de una colección de elementos orgánicos e inorgánicos, recolectados en el tránsito por los diferentes lugares propuestos en las expediciones.
Estos lugares dan cuenta de diferentes ecosistemas que se han construido a lo largo del tiempo y en los que es posible indagar sobre las relaciones que establecen el ser humano con su entorno, así como los diferentes elementos que los componen entre sí.
¿Qué tiene para decirnos un elemento de su situación en el territorio? ¿Cuál es su relación con la intervención del ser humano? ¿Qué vemos en las cosas? ¿Qué escapa a nuestra mirada? ¿Es posible dar la palabra a estos elementos? ¿Es posible construir un relato colectivo entre estos materiales, sus voces y nuestras intervenciones?
2020-2021
︎ MACMO
︎︎︎http://macmo.uy/?actividades=coleccion-bahia-de-montevideo
Fotografías de expedición y muestras de Isla Libertad
︎︎︎

︎ MACMO
︎︎︎http://macmo.uy/?actividades=coleccion-bahia-de-montevideo
Fotografías de expedición y muestras de Isla Libertad
︎︎︎